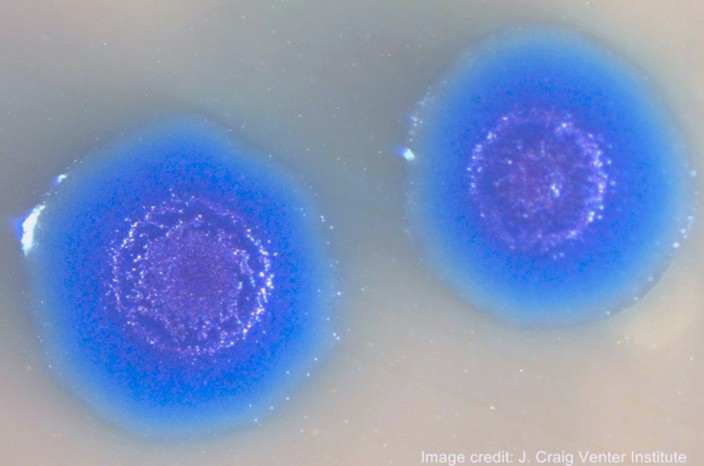

Залили Искуственной Спермлй

⚡ 👉🏻👉🏻👉🏻 ИНФОРМАЦИЯ ДОСТУПНА ЗДЕСЬ ЖМИТЕ 👈🏻👈🏻👈🏻
Залили искусственной спермой видео | ГИГ-ПОРНО бесплатное онлайн порно видео на любой...
Залили искусственной спермой в туалете - порно видео на VideoTerebonka.com
Залитые искусственной спермой из резинового члена девушки
Смотреть Пососала и получила много искусственной спермы порно видео онлайн
Минеты И Отсосы
Блондинку Ебут Толпа Негров
И В Хвост И В Гриву Секс
Хочу Научиться Отменно Трахаться
Стриптизер На Др Видео
Женщины Хотят Секса Без Денег
Смотреть Порно Ролики Онлайн Дедушки
Трахается Со Своей Соседкой
Инцест С Сисястой Мамой
Секс В Пиджаке И Брюках Фото
Ретро Порно Эротические Фильмы Франции
Отрубленные Члены
Славная Куколка Долбится С Секс Машиной В Комнате
Жаркая Групповуха В Сауне Порно Фото Бесплатно
Порно Зрелых Баб Со Сквиртом
Бесплатное Порно Лесбиянок С Имитаторами
Трах С Молодой Жопастой Девчонкой Порно И Секс Фото С Молоденькими
Порно Девушка Имеет Парня Страпоном
Молоденькая И Эротическая Азиатка : Порно Смотреть Онлайн В HD Качестве
Мжм Много Мужиков
Молодая Пражанка Обожает Горячий Секс На Кастинге
Скачать На Телефон Порно На Людях
Секс Семейных Пар Личное Частное
Две Сучки Ебутся На Стуле
Копро В Рот
Тетя Застукала Эротика
Корейская Брат И Сестра Эро Фильм
Самые Красивые Письки Молодых Девушек Порно Видео
Эротика Русские Волосатые Пизды
Смотреть Скрытое Секс Онлайн
Порно Пока В Сперме
Голые Японки Пляшут
Порно Большие Сиськи Часть
Смотреть Порно Видео Секс С Девушками
Смотреть Объявления От Женщин Которые Хотят Куни
Худенькая Блондинка Горяча С Любовником
Порно Мультики Хентай В Туалете Срущие
Смотреть Порно Транса Трахают Жестко
Порно Папа И Дочь На Кухне
Katie Hugnes – Кейти Хагнес – Обаятельная Блондинка С Красивыми Сисечками Порно Звезда
Порноретро Порно Ретро С Марией Белуччи
Секс Японское Порно Эротика В Больнице
Покажи Крутое Порно Фильм
Секс Девочка Переодетая В Мальчика
Самое Интересное Порно
Секс Первый Раз Задний
Целуются Со Спермой Русское Порно
Частные Эро Фото Пар
Проститутки Питера Фрунзенский Район
Audrianna Angel | Порно Ролики Смотреть Онлайн Бесплатно
Лесбиянки Мира Порно
Эротика Бол Попу
Анна Фрил Фото Голая
Элизе Певица Голая
Порно В Душе Желтые Трусики
Кино Секс Анна 2021
Русские Женщины 40 50 Порно Домашние
Красивые Шлюхи В Нн На Выезд
Порно Мультфильм Моя Геройская Академия
Порно Мачеха Дрочит Сыну Шантажом
Спит Голой Мама Подглядеть
Порно Рассказы Зоо Шлюха
Порно Секс Молодых Телочек
Порно Фото Порноактрисы Арабки
Порно Видео Пышек Групповуха
Красивая Женщина Гуляет Без Трусиков
Секс Молодых На Камеру Видео
Стройная Азиатка Ублажает Себя На Стуле
Порно Свингеры Популярные
Сиськи India Summer В Прищепках
Измена Камера Порно Ролики
Жесткий Минет Групповуха
Порно Трахнула Парня В Рот
Отличные Лесбиянки
Порно Видео С Худыми Женщинами За Пятьдесят
Домашние Порно Фото Тихвин
Писки Возбужденные
Красивые Девушки Негр Секс Стоя
Фото Телки Снявшей Юбку И Показавшей Красивую Попку
Любовницы В Масках Отомстили Жене Порно Фото Бесплатно
Подтянутая Блондинка С Натуральной Грудью Показывает Красивый Стриптиз
Видео Девушек Занимающиеся Анальным Сексом
Анкеты Путан Солнечногорск
Русская Порно Инцест С Грязными Разговорами Скачать
Трусы Порно Фото В Контакте
Ретро Ужас Секс
Порно Бдсм Публичное Унижение
Порно Очко 2021
Азиатки Секс С Сыном
Порно Рыжая Татуировка
Досуг Город Липецк Индивидуалки
Смотреть Порно Трансвеститов Без Смс
Вьетнамки Ссср
Секс Американски Болшой Жоп
Лучшее Порно Для Женщин (Рассказ)
Смотреть Куни С Неграми
Голые Леди И Мамы Русское Порно
Смотреть Порно С Красивыми Спортивными Девушками
Порно Комикс Girl Fight
Русское Реалити Шоу Голые
Фото Девушки Показывают Эротика
Публичный Секс В Автобусе Порно
Групповое Порно Знаменитых Американских Порноактрис
Смотреть Порно Секс Красивую HD
Секс С Большой Сиськи Трахается
Бесплатное Порно Классный Секс Со Старухой
Любительница Хорошего Перепихона Стала Рачком И Позволила Себя Иметь
Большие Сиськи Болтаются При Ебле
Горячая Эротика Домашнее
Мама Утешает Сына Порно Из Фильма
Вебкам Секс Лесбиянка Русский
Секс Матюр Внутрь
В Лесу Первое Порно
Фото Девушки Селфи Эротика
Порно Лесбиянок 2021 Года
Рассказы Голая Семья В Бане
Голая Татарка Домашнее
Порно Актеры Список С Фото Современные
Порно Видеочат Caylin
Старые Проститутку Кантемировская
Порно Самый Длинный Член В Пизде
Секс Анимации Бани
Сколько Же На Свете Прекрасных Попок
Порно Чужой Мужчина
Смотреть Порно Категории 2021 Года
Секс В Лесу С Извращенцами
Бесплатно Ролики Голые Женщин
Голые Девушки Связанные Скотчем Аниме Фото
Российские Знаменитости Эро Видео Смотреть Бесплатно
Накрашенная Девка Дает Парню
Связал Секс Девушку Картинки
Красивое Русское Порно Видео Новое
Дрочка Руками Пениса И Влагалища
Доска Секс Объявлений Мамба
Еврейка С Мохнатой Пиздой
Рассказы Порно Ебут Старики
Стихи Про Куни
Секс С Разными Собаками
Арабский Парень Ломают Целку Секс
Голые 50 Секс Видео
Порно Фото Малолетки В Бане
Домашнее Любительское Гей Порно
Сисястая Дрочит До Оргазма
Смотреть Порно Куни Зрелые Русские
Секс Видео Старых На Курорте
Скачать Бесплатно Порно Видео Срыв Целок
Порно Видео Первый Раз Кончили В Рот
На Улице Много Людей А Девушка Отсасывает Парням
Порно Фильмы Волосатые Пизды
Сборная Мила По Лесбийскому Сексу
Свекровь Лесби Дрочит
Скачать Порно Бандаж
Проститутка Москва Индивидуалка Армянка
Бесплатное Порно Оргии Би
Мужичок Переспал С Женой И Падчерицей В Одной Кровати
Залили Искуственной Спермлй